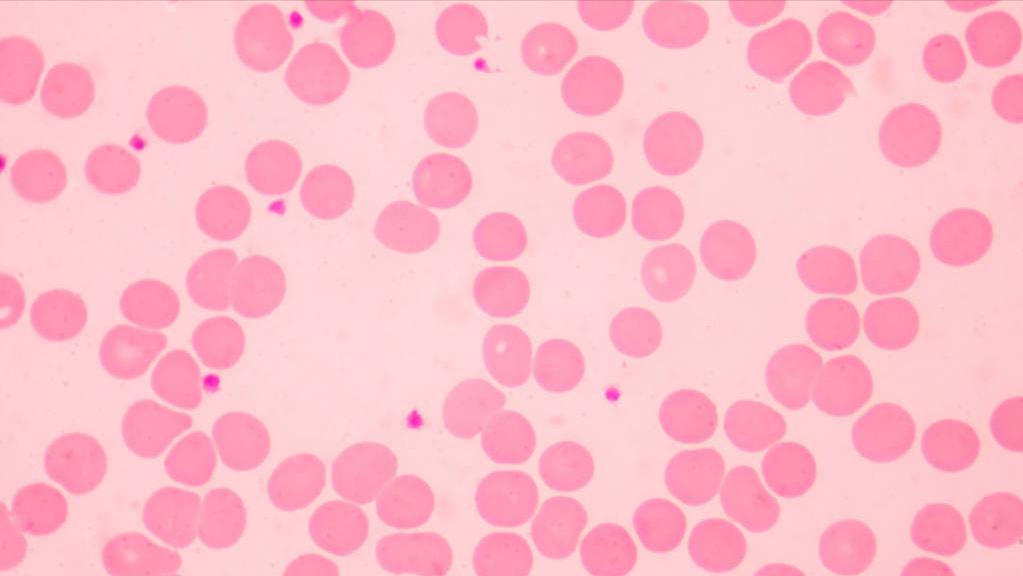
血管外科刁永鹏主任,北京医院血管外科刁永鹏

无论是生病还是体检,都有抽血化验的时候,所以怎么能够读懂化验单,是很多朋友非常关心的一个问题。

在门诊把化验结果给大夫一看,大夫非常快的看完,所以有很多朋友很奇怪,这个医生是不是认真的看了,怎么会看这么快呢?所以我在这里想跟大家讲一讲,如何能够快速准确判断化验有没有问题。

首先跟大家说说,如何能够快速地看血常规的化验单,因为里面项目非常的多,但是医生主要关注的就这五六项,是哪五六项呢?

1血红蛋白,也就是我们说的血色素,如果血红蛋白这个指标明显低于正常值120-160,如果低于120的话,我们认为就是贫血的状态。

2红细胞压积。红细胞压积能说明红细胞整个的体积,占所有的血液里面的比例是多少。如果这个比例低于范围的最低值38的话,也同样能说明有贫血的问题。

3白细胞的计数。白细胞计数一般来说是4-10,如果大于10的话,就说明有感染。但是同样还有个非常重要的指标,就是中性粒细胞的百分比,这个指标跟白细胞计数一样,也能反应是不是有感染的问题。因为有些老年人出现感染之后,他的白细胞因为身体条件比较弱,白细胞计数反应不出来,所以他的中性粒细胞的比例就会升高,所以一般来说不能超过75%,如果大于75%的话,就说明有感染。
4另外像嗜酸性粒细胞的比例,如果嗜酸性粒细胞的比例高于正常值的上限,就说明可能有过敏的问题。

5血小板的计数。血小板计数非常重要,一般来说正常是在100-300之间,如果低于100,有可能是血小板明显的下降,如果高于300的话也是异常的增高。提醒大家,这些参考值每个医院化验的范围不一样,所以要根据拿到的化验单的具体数值来对比,看看刚才提到的这几项是不是有异常。

有心血管外科方面问题的朋友可以关注我,私信或者留言您的问题,我会在空闲时间给您进行解答!